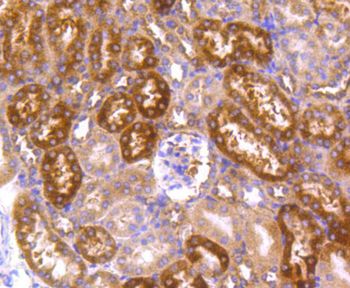
Hsp90 alpha Recombinant Rabbit Monoclonal Antibody
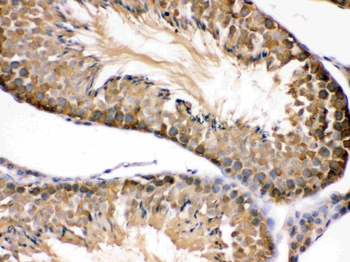
Hsp90 beta/HSP90AB1 Antibody
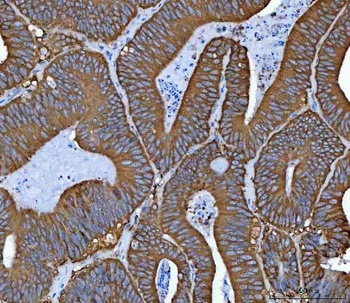
Hsp90 alpha + beta HSP90AA1 Rabbit Monoclonal Antibody
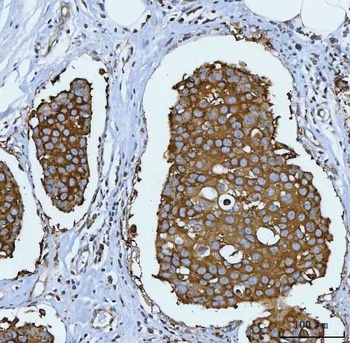
Hsp90 alpha + beta HSP90AA1 Rabbit Monoclonal Antibody

You have no items in your shopping cart.
- GRP94 Rabbit Polyclonal Antibody [orb10752]Featured

FC, IF, IHC-Fr, IHC-P, WB
Human, Mouse, Rat
Bovine, Canine, Equine, Gallus, Porcine, Rabbit
Rabbit
Polyclonal
Unconjugated
50 μl, 100 μl, 200 μl - Hsp27 Recombinant Rabbit Monoclonal Antibody [orb1499379]Featured

FC, ICC, IF, IHC-Fr, IHC-P, WB
Human, Mouse, Rat
Rat
Rabbit
Recombinant
Unconjugated
25 μl, 100 μl, 50 μl - HSP70 Rabbit Polyclonal Antibody [orb157591]Featured

FC, ICC, IF, IHC-Fr, IHC-P, WB
Human, Mouse, Rat
Bovine, Gallus, Porcine, Rabbit, Sheep
Rabbit
Polyclonal
Unconjugated
100 μl, 200 μl, 50 μl - HSP27 Rabbit Polyclonal Antibody [orb10845]Featured

FC, IF, IHC-Fr, IHC-P, WB
Human, Rat
Bovine, Canine, Mouse, Porcine
Rabbit
Polyclonal
Unconjugated
50 μl, 100 μl, 200 μl - Hsp90 alpha Recombinant Rabbit Monoclonal Antibody [orb1499397]Featured

ICC, IF, IHC-Fr, IHC-P, WB
Human, Mouse, Rat
Human, Mouse, Rat
Rabbit
Recombinant
Unconjugated
25 μl, 100 μl, 50 μl - Hsp60/HSPD1 Antibody (monoclonal, 6G2) [orb570314]
FC, ICC, IF, IHC, WB
Human, Mouse, Rat
Mouse
Monoclonal
Unconjugated
100 μg - Hsp90 beta/HSP90AB1 Antibody [orb315144]
ICC, IF, IHC, WB
Human, Mouse, Rat
Rabbit
Polyclonal
Unconjugated
100 μg FC, ICC, IF, IHC, IP, WB
Human, Mouse, Rat
Rabbit
Monoclonal
Unconjugated
100 μl- Hsp90 alpha/HSP90AA1 Antibody [orb196259]
FC, ICC, IF, IHC, WB
Human, Mouse, Rat
Rabbit
Polyclonal
Unconjugated
100 μg - HSP70 Rabbit Polyclonal Antibody [orb10848]Featured

FC, ICC, IF, IHC-Fr, IHC-P, WB
Human, Mouse, Rat
Bovine, Gallus, Rabbit, Sheep
Rabbit
Polyclonal
Unconjugated
100 μl, 50 μl, 200 μl